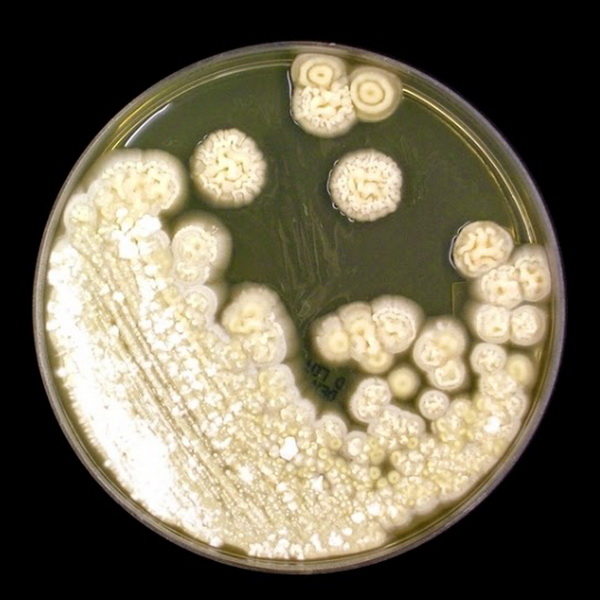
Мазок на флору покажет молочницу

Для чего делается анализ?
С симптомами молочницы знакомы практически все. Эти творожистые выделения, сопровождающиеся зудом и жжением, сложно перепутать с другими недугами.
Но зачем же необходимо проводить анализ на молочницу у женщин?
- Прежде всего, такой анализ обязательно берется у беременных женщин. В этот период организм становится особенно уязвимым к различным инфекциям, и наличие кандидоза у матери может негативно сказаться на здоровье ребенка.
- Во-вторых, анализ на молочницу помогает точно установить диагноз, так как существует несколько видов грибков. Это также позволяет контролировать процесс лечения, поскольку бывает, что грибок не реагирует на препараты, назначенные гинекологом.
Кроме анализов, врач проведет опрос, в ходе которого его интересуют симптомы, их продолжительность и интенсивность, а также какие средства использовались для самолечения и на протяжении какого времени. Честные ответы на эти вопросы помогут подобрать наиболее эффективное лечение. Также обязательным является визуальный осмотр.
Анализ на кандидоз также необходим для исключения возможности наличия других заболеваний. Порой симптомы могут быть размытыми, что затрудняет врачу постановку правильного диагноза.
Рекомендуется периодически сдавать анализы после выздоровления, чтобы не упустить момент, если болезнь решит вернуться.
Во время профилактического осмотра гинеколог берет мазок на молочницу, чтобы иметь возможность диагностировать заболевание на ранних стадиях его развития.
Врачи отмечают, что для выявления молочницы, или кандидоза, необходимо провести несколько анализов. Основным методом диагностики является микроскопическое исследование vaginalного мазка, которое позволяет обнаружить грибки рода Candida. Также часто назначают посев на питательные среды, что помогает определить вид грибка и его чувствительность к противогрибковым препаратам. В некоторых случаях может потребоваться анализ крови на антитела к Candida, особенно если молочница проявляется часто или имеет рецидивирующий характер. Важно, чтобы пациентка обратилась к врачу при первых симптомах, так как своевременная диагностика и лечение помогут избежать осложнений и улучшить качество жизни.

Виды анализов на кандидоз
Какие анализы необходимо сдать при молочнице? Существует четыре основных типа:
- микроскопическое исследование мазка,
- посев с определением чувствительности к лекарственным средствам,
- полимеразная цепная реакция (ПЦР),
- иммуноферментный анализ.
Эти методы отличаются друг от друга по способу выявления грибка или его следов в организме. Какой анализ является наиболее эффективным при молочнице? На этот вопрос сложно ответить однозначно, так как некоторые из них лучше подходят для острого течения заболевания, а другие – для случаев, когда есть лишь подозрение на наличие грибка. Иногда может потребоваться проведение нескольких анализов для более точной диагностики.
Кроме того, для повышения точности результатов анализа на молочницу важно правильно подготовиться к его сдаче. Однако подробности о подготовительных мероприятиях должен объяснить врач, который назначил исследование.
Важно помнить: необходимо исключить половые контакты за 2–3 дня до забора материала и избегать любых процедур, направленных на дополнительную очистку слизистой влагалища.
Некоторые женщины удивляются, когда врач рекомендует сдать анализ мочи при молочнице, так как более старшее поколение привыкло к мазку. Однако некоторые методы диагностики позволяют получать образцы из различных биологических жидкостей организма, включая мочу.
| Название анализа | Что выявляет | Особенности |
|---|---|---|
| Микроскопическое исследование мазка (нативная микроскопия) | Наличие дрожжеподобных грибов рода Candida, псевдомицелия, спор | Быстрый и доступный метод, позволяет оценить количество грибов и наличие воспаления. |
| Культуральное исследование (посев на питательные среды) | Вид гриба Candida, его чувствительность к противогрибковым препаратам | Более точный метод, позволяет определить конкретный вид гриба и подобрать эффективное лечение. Результат готов через несколько дней. |
| ПЦР-диагностика (полимеразная цепная реакция) | ДНК грибов рода Candida | Высокочувствительный и специфичный метод, позволяет выявить грибы даже при их небольшо количестве. |
| Экспресс-тесты (тест-полоски, тест-системы) | Изменение pH влагалища, наличие ферментов, характерных для Candida | Быстрый, но менее точный метод для первичной диагностики. Не заменяет полноценное лабораторное исследование. |
| Анализ крови на антитела к Candida | Наличие иммунного ответа организма на грибы Candida | Используется редко для диагностики молочницы, чаще при системных кандидозах или для оценки иммунного статуса. |
Микроскопия мазка
Для проведения данного анализа берется мазок или соскоб на кандидоз у женщины. Соскоб следует делать с участка, где предполагается наличие заболевания. Полученный мазок тщательно исследуется под микроскопом, что позволяет специалисту визуально обнаружить грибок в образце. Эта процедура не вызывает болезненных ощущений, однако с помощью микроскопии невозможно точно определить, какой именно вид грибка присутствует у пациента, а также подобрать индивидуальное лечение. Для более точной диагностики врачу может потребоваться взять дополнительный мазок на флору со слизистой оболочки рта.
Молочница, или кандидоз, является распространённым заболеванием, вызванным грибами рода Candida. Многие люди интересуются, какие анализы помогут выявить это заболевание. В первую очередь, врачи рекомендуют сдать анализы на микрофлору, которые позволяют определить наличие грибов в организме. Это может быть мазок из влагалища у женщин или анализ мочи у мужчин. Также часто назначают посев на грибки, который помогает выявить не только наличие Candida, но и её чувствительность к противогрибковым препаратам. В некоторых случаях может потребоваться анализ крови, чтобы оценить общее состояние иммунной системы. Люди отмечают, что своевременная диагностика и правильное лечение помогают быстро справиться с молочницей и избежать рецидивов.

Посев микрофлоры влагалища
Диагностика кандидоза, известного также как молочница, у женщин дает возможность точно определить причины возникновения заболевания. Кроме того, она позволяет выяснить, какой именно вид грибка присутствует в организме и как он реагирует на различные лекарственные средства.
В зависимости от симптомов, которые описывает пациентка, и предполагаемого места локализации инфекции, образцы для анализа могут быть взяты из мокроты, мочи, кала, а также с поверхности ротовой полости, уретры, влагалища и верхних дыхательных путей.
Собранный материал помещается в питательную среду, где исследователь наблюдает за процессом роста. Если в образце присутствует грибок, он начнет активно размножаться, и вскоре станет заметен. Однако на этом диагностика не завершается. Исследователь начинает применять различные противогрибковые препараты на разросшиеся колонии грибков. Таким образом, диагностика кандидоза или молочницы помогает подобрать наиболее эффективные медикаменты для лечения.
ПЦР анализ
Анализ на наличие молочницы с использованием полиразмерной цепной реакции (ПЦР) стал весьма распространенным и часто применяется в медицинских учреждениях. Для проведения исследования можно использовать различные образцы, такие как венозная кровь, слюна, спинномозговая жидкость, мокрота, моча и околоплодные воды. Из собранного материала исследователь извлекает ДНК, после чего многократно воспроизводит процесс копирования. Затем полученные цепочки ДНК разделяются, и в них добавляются специальные реагенты, которые вызывают свечение патогенных микроорганизмов. Этот диагностический метод обладает рядом преимуществ:
- он позволяет обнаружить не только молочницу, но и множество других заболеваний, поскольку исследование проводится на уровне ДНК;
- высокая чувствительность метода позволяет выявлять инфекцию даже при минимальном количестве микроорганизмов;
- для анализа подходят все биологические жидкости организма, а также соскобы с эпителия;
- процесс исследования занимает немного времени, и результаты можно получить примерно через 6 часов после сдачи анализа.
Однако у данного метода есть и недостатки. Главным из них является то, что при неправильном заборе биоматериала вероятность получения ложного результата значительно возрастает.

Иммуноферментный анализ
Данный метод диагностики основывается на способности организма производить антитела в ответ на попадание антигенов. Для проведения анализа используются образцы спинномозговой жидкости, крови и околоплодных вод. Из названия метода ясно, что для выявления микроорганизмов применяются как иммунные, так и ферментативные реакции. Это сочетание позволяет установить, находится ли заболевание в острой или хронической стадии, произошло ли обострение и является ли пациент носителем инфекции. Тем не менее, зачастую требуется повторная сдача анализа через определённый промежуток времени для более точного определения диагноза.
Содержание грибков в норме
Иногда возникает ситуация, когда анализ на флору показывает наличие молочницы, но гинеколог утверждает, что кандидоза нет. В этом случае не стоит сразу обвинять специалиста в недостаточной квалификации и спешить искать нового врача. Дело в том, что грибок может присутствовать в небольших количествах у большинства людей. Если вы не испытываете никаких дискомфортных ощущений, лучше сосредоточиться на укреплении иммунной системы, а через некоторое время повторно сдать анализ.
Своевременное обследование на кандидоз поможет подтвердить или опровергнуть диагноз. Поэтому не стоит откладывать визит к врачу и следует как можно быстрее пройти все необходимые процедуры.
Может показаться, что анализы – это ненужная трата времени и денег, однако быстрая и точная диагностика позволит избежать лишних затрат на лечение, которое не принесет результата.
Также важно обратиться к врачу и сдать анализ, если неприятные симптомы появились впервые. Женщина, которая никогда не сталкивалась с молочницей, может перепутать ее проявления с признаками других заболеваний. Даже если врач не выявит у вас кандидоза, забота о собственном здоровье никогда не будет лишней.
Вопрос-ответ
По какому анализу можно определить молочницу?
ПЦР-диагностика. Метод полимеразной цепной реакции (ПЦР) используется для обнаружения и идентификации ДНК грибков Candida в биологических образцах.
Как гинекологи проверяют молочницу?
Методы диагностики вагинального кандидоза (молочницы). Для этого гинеколог берет влагалищный мазок и изучает его под микроскопом. Если диагноз подтвержден, пациентке рекомендуют сдать анализ мочи и крови на сахар, поскольку иногда молочница — симптом диабета.
Какой тест показывает молочницу?
Для диагностики молочницы (кандидоза) обычно проводят микроскопическое исследование vaginalного мазка, где ищут грибки рода Candida. Также может быть выполнен посев на питательные среды для подтверждения наличия грибка и определения его чувствительности к противогрибковым препаратам.
Можно ли по анализу крови определить кандидоз?
Серологические тесты могут служить важным дополнением к микробиологическим методам диагностики инвазивного кандидоза. Определение IgG в крови дает положительный результат в большинстве случаев системного кандидоза (чувствительность и специфичность теста составляют около 80%).
Советы
СОВЕТ №1
Перед тем как сдавать анализы, обязательно проконсультируйтесь с врачом. Он поможет определить, какие именно тесты необходимы в вашем случае, и объяснит, как правильно подготовиться к их сдаче.
СОВЕТ №2
Обратите внимание на симптомы молочницы, такие как зуд, жжение и необычные выделения. Это поможет вам более точно описать свои ощущения врачу и ускорить процесс диагностики.
СОВЕТ №3
Не забывайте о важности соблюдения гигиенических норм. Используйте только мягкие моющие средства и избегайте синтетического нижнего белья, чтобы снизить риск повторного возникновения молочницы после лечения.
СОВЕТ №4
После получения результатов анализов обязательно обсудите их с врачом. Он сможет объяснить, что означают результаты, и предложить наиболее эффективные методы лечения.